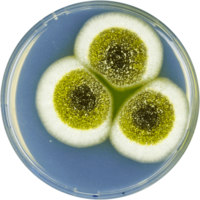
Aspergillus robustus cya.png

Aspergillus robustus
| Aspergillus robustus | ||||||||||
|---|---|---|---|---|---|---|---|---|---|---|
| ||||||||||
| Научная классификация | ||||||||||
|
Домен: Царство: Подцарство: Отдел: Подотдел: Класс: Подкласс: Порядок: Семейство: Род: Вид: Aspergillus robustus |
||||||||||
| Международное научное название | ||||||||||
| Aspergillus robustus | ||||||||||
| ||||||||||
Aspergillus robustus (лат. Aspergillus robustus) — вид грибов рода Aspergillus (рода Аспергиллус семейства Трихокомовые отдела аскомицетов.
Описание
Aspergillus robustus, согласно правилам биологической систематики, обозначается как таксон Aspergillus robustus .
Как и другие аскомицеты, представители этого вида характеризуются разделённым на клетки мицелием и особыми органами полового спороношения — асками (или сумками). Аскомицеты составляют с базидиомицетами подцарство высших грибов.
Литература
- Kirk P. M., Cannon P. F., Minter D. W., Stalpers J. A. Ainsworth and Bisby's Dictionary of the Fungi. — 10th editon. — CAB International. — ISBN 978 0 85199 826 8.
Ссылки
- Профиль на сайте Национального центра биотехнологической информации США (NCBI)
- Профиль на сайте «Энциклопедия жизни» (архив)
- Профиль в проекте MycoBank
